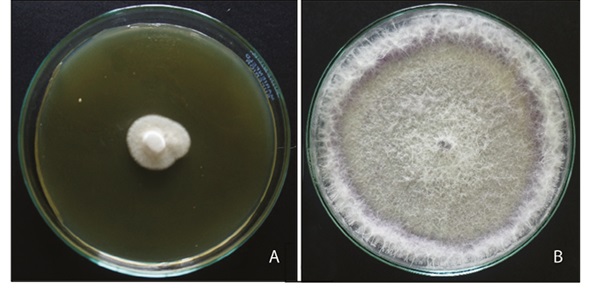
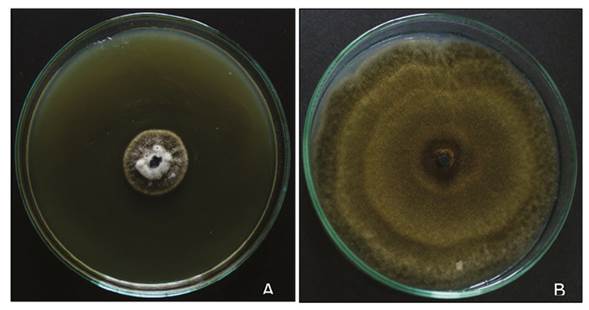

Resumen: Introducción.Fusariumsp yAlternariasp son hongos fitopatógenos que causan serios problemas en cultivos y en el sector agrícola, situación que genera pérdidas económicas importantes. Además, debido a la producción de micotoxinas representan una amenaza para la salud de los consumidores y para las plantas. Objetivo. Evaluar la actividad antifúngica del extracto etanólico de hojas de borraja (Borago officinalis) sobreFusariumsp yAlternariasp. Materiales y métodos. Se realizó la identificación cualitativa y cuantitativa de los metabolitos secundarios presentes en el extracto etanólico deB. officinalis, posteriormente,Fusariumsp yAlternariasp. fueron secuenciadas por estudios moleculares mediante la amplificación de la región ITS (espaciador transcribible interno) del ADN ribosomal y finalmente, se evaluó la actividad antifúngica del extracto sobre las cepas previamente reconocidas mediante la prueba de crecimiento radial por técnica de difusión en agar. Resultados. El extracto etanólico de las hojas deB. officinaliscontiene alcaloides, flavonoides, fenoles, polifenoles y saponinas, de los cuales los polifenoles y los flavonoides presentan una concentración de 19,08±0,01 miligramos equivalentes de ácido gálico (EAG) por gramo de extracto y 28,12±0,06 miligramos equivalentes de catequina (Qe) por gramo de extracto, respectivamente. La secuenciación de los aislamientos evaluados mostró una alta similitud (>98%) con varias especies de Fusarium sp yAlternariasp, mientras que los ensayos de actividad antifúngica del extracto mostraron actividad fungistática por parte deB. officinalisal ser 16 mg.l-1el tratamiento más efectivo para ambos aislamientos evaluados con un porcentaje de inhibición de 90,3±0,9% paraAlternariasp y 86,6±2,2% paraFusariumsp, dondeAlternariasp presentó mayor susceptibilidad frente al extracto de las hojas deB. officinalis. Conclusión. Los resultados de esta investigación proporcionan uno de los primeros reportes de la actividad antifúngica deBorago officinalissobreFusariumsp yAlternariasp.
Palabras clave: Fusarium sp, Alternaria sp, ITS, metabolitos secundarios, maleza..
Abstract: Introduction.Fusariumsp andAlternariasp are phytopathogenic fungi that cause serious problems in crops and in the agricultural sector, situation that generates significant economic losses. In addition, due to the production of mycotoxins, they pose a threat to the health of consumers and plants. Objective. To evaluate the antifungal activity of the ethanolic extract of borraja leaves (Borago officinalis) onFusariumsp andAlternariasp. Materials and methods. Qualitative and quantitative identification of the secondary metabolites present in the ethanolic extract ofB. officinaliswas carried out, later,Fusariumsp andAlternariasp were sequenced by molecular studies by amplifying the ITS (internal transcribable spacer) region of ribosomal DNA and finally, antifungal activity of the extract on previously recognized strains was evaluated by means of radial growth test using agar diffusion technique. Results. Ethanolic extract ofB. officinalisleaves contains alkaloids, flavonoids, phenols, polyphenols and saponins, of which polyphenols and flavonoids have a concentration of 19.08±0.01 milligrams equivalent of gallic acid (EAG) per gram of extract and 28.12±0.06 milligrams equivalent of catechin (Qe) per gram of extract, respectively. Molecular sequencing of the evaluated isolates showed a high similarity (> 98%) with several species ofFusariumsp andAlternaria sp, while antifungal activity tests of the extract showed fungistatic activity byB. officinalis, with 16 mg.l-1being the most effective treatment for both isolates evaluated with an inhibition percentage of 90.3±0.9% forAlternariasp and 86.6±2.2% forFusariumsp, whereAlternariasp presented greater susceptibility to the extract ofB. officinalisleaves. Conclusion. The results of this investigation provide one of the first reports of the antifungal activity ofBorago officinalisonFusariumsp andAlternariasp.
Keywords: Fusarium sp, Alternaria sp, ITS, secondary metabolites, weed..
Artículo
Evaluación in vitro del extracto etanólico de hojas de borraja (Borago officinalis) contra la actividad fungistática
In vitro evaluation of ethanol extract from borraja leaves (Borago officinalis) against fungistatic activity
Recepción: 15 Mayo 2020
Aprobación: 21 Septiembre 2020
Hongos fitopatógenos comoFusariumsp yAlternariasp producen micotoxinas las cuales provocan daños graves a frutas y vegetales durante los procesos de recolección, transporte y almacenamiento, aspecto que afecta su vida útil, además de hacerlos no aptos para el consumo humano (Galvanoet al. 2001, Pavón-Morenoet al. 2012, Tirumale y Wani 2018). Estos hongos son responsables del marchitamiento vascular, decadencia radicular, putrefacción, lesiones necróticas, manchas en hojas y tallos. Asimismo, su presencia también representa una amenaza para la salud de personas consumidoras debido a la producción de micotoxinas (Agrios 2005, Pal y Gardener 2006, Pavón-Morenoet al. 2012).
Colombia representa regiones susceptibles al ataque de organismos fitopatógenos capaces de generar pérdidas millonarias en el sector agrícola. Es un sector creciente que representa el 11,9% del territorio nacional (5 099 744 ha). De este, el 40,2% se utiliza para cultivos como café, palma de aceite, caña de azúcar, entre otros, y un 20,3% se dedica a los cereales (DANE 2017). Adicionalmente, se encuentran los cultivos de musáceas como banano del subgrupo Cavendish, que ocupan un área de 561 922 ha del territorio, donde el 11,27% del área es destinado para su producción y exportación y el otro 88,76% es destinado para el consumo interno (ICA 2019).
El interés generado por empresas exportadoras para ingresar en los mercados internacionales de productos provenientes de la actividad agrícola, ha promovido el incremento de los estándares de calidad que a la vez generan sobrecostos de producción, entre los cuales resalta el control de plagas y enfermedades. Tradicionalmente, el control de enfermedades de origen fúngico ha dependido del tratamiento con agroquímicos (Chávez y Aquino 2012). Los agroquímicos representan un riesgo para el ambiente y la salud humana, los cuales pueden llegar a ser cancerígenos; además su uso genera residuos que contaminan el suelo, el aire, los cuerpos de agua y en algunos casos, son perjudiciales para la biota responsable del control natural de plagas y patógenos potenciales (Abdel-Monaimet al. 2011, Rodríguez-Maturinoet al. 2015, Tirumale y Wani 2018). Ante este problema, una de las posibles alternativas que permiten reducir las enfermedades en plantas causadas por hongos fitopatógenos es el uso de extractos vegetales, los cuales han demostrado tener efectos como controladores de ácaros, roedores, nematodos, bacterias, virus, hongos e insectos (Celiset al. 2009, Boaduet al. 2011). Además, poseen poca o ninguna toxicidad contra el ser humano y son rápidamente degradados en el suelo en comparación con los agroquímicos utilizados actualmente (Coratoet al. 2010, Mahloet al. 2010, Rodríguez-Maturinoet al. 2015).
Para un país en el que los sistemas agrícolas representan una de las formas de uso del suelo más importantes, a su vez deberá ser parte de sus prioridades, la cual depende en parte, del buen mantenimiento y control biológico de fitopatógenos (Moreno-Velandiaet al. 2018). Complementariamente, se debe considerar que Colombia posee entre 40 000 y 45 000 especies de plantas lo que lo convierte en el segundo país a nivel mundial de diversidad de especies de las cuales al menos 6000 poseen propiedades medicinales (Giraldo-Quinteroet al. 2015), tradicionalmente es un país con una larga historia de uso de plantas como alimentos, medicina, vestuario y rituales ancestrales (Gómez-Fonnegra y Villa-Londoño 2011).
Especies de plantas consideradas como malezas, tal comoB. officinalis, son ampliamente utilizadas con fines medicinales y culinarios, entre los que resaltan como una fuente rica de ácido gamma linoleico, precursor de prostaglandinas antiinflamatorias; además, de poseer actividad antioxidante laxante, emoliente diurético entre otros (Galleet al. 1993, Ratz-Łykoet al. 2014, Fernandeset al. 2019). Diversos estudios sobre las propiedades fitoquímicas deB. officinalistambién han identificado la presencia de actividad antimicrobiana frente a diversos patógenos de interés (Mhamdiet al. 2009, Arévalo 2009, Nieto-Navarro 2012, Basaret al. 2013, Miceliet al. 2014, Ávila 2016).
Algunos extractos naturales presentan actividad antifúngica por sus principios activos o “metabolitos secundarios”, los cuales son compuestos químicos que suelen estar presentes en fuentes botánicas, además, no representan un peligro para la salud humana (Locket al. 2016). Los metabolitos secundarios presentes pueden ser terpenoides, compuestos fenólicos, fenilpropanoides, estilbenos, alcaloides, saponinas, entre otros (Dixon 2001, Okwu y Nmamdi 2008). Algunos como los fenoles y flavonoides son responsables de actividad antimicrobiana, reportados principalmente contraEscherichia coliyCandidaspp (Cushnie y Lamb 2005, Coratoet al. 2010, Echavarríaet al. 2016, Abuet al. 2017, Jasso de Rodríguezet al. 2019). En el caso de hongos se considera que la actividad antimicrobiana de los metabolitos secundarios, está relacionada con la inhibición de la germinación de los conidios por parte de los hongos o por la inactivación de la síntesis de aminoácidos esenciales (Cushnie y Lamb 2005, Pietarinenet al. 2006, Kappelet al. 2008, De Castroet al. 2010).
En la actualidad existen pocos datos publicados acerca de la actividad deB. officinalissobre especies de hongos fitopatógenas, por lo cual el objetivo de este estudio fue evaluar in vitro la actividad antifúngica del extracto etanólico de hojas de Borraja (B. officinalis)sobre hongos fitopatógenos productores de micotoxinas que provocan daños graves a cultivos de frutas y verduras comoFusariumsp yAlternariasp. Para lograr este objetivo, se identificaron metabolitos secundarios presentes enB. officinalis; además, se cuantificó el contenido de fenoles y flavonoides totales presentes en el extracto etanólico de hojas deB. officinalis. Además,Fusariumsp yAlternariasp fueron caracterizados por estudios moleculares y bioinformáticas mediante la amplificación de la región ITS del ADN ribosomal y finalmente, se determinó el porcentaje de inhibición del crecimiento del extracto de las hojas deB. officinalissobre los aislamientos previamente identificados mediante la prueba de crecimiento radial por técnica de difusión en agar.
Obtención del material vegetal. El material vegetal de la maleza conocida con el nombre de Borraja (B. officinalis) fue obtenido en noviembre de 2018 en Mendoza. Durante ese proceso se consideró que las plantas fueran ejemplares adultos y no presentaran signos de enfermedad aparente, como la presencia de pigmentos marrones, amarillos u oscuros en las hojas. Con el fin de corroborar la especie utilizada, 4 muestras deB. officinalisfueron prensadas, con el protocolo para la entrega de colecciones botánicas y depositadas en el herbario de la Universidad Nacional de Colombia con la utilización del servicio de identificación taxonómica para muestras botánicas para proporcionar la correcta clasificación.
Obtención del extracto. El extracto de las hojas deB. officinalisse obtuvo a partir de 1000 g de hojas frescas separadas manualmente del tallo. Estas fueron desinfectadas con hipoclorito de sodio 1% y, posteriormente, lavadas con agua destilada y secadas al aire durante 24 horas a temperatura ambiente; después, fueron trituradas con una picadora y sumergidas en etanol 98% en relación 1:2 en un recipiente de vidrio. Posteriormente, el recipiente fue envuelto en papel aluminio y se dejó en reposo durante 10 días. Después, el extracto fue filtrado y el material vegetal se colocó de nuevo en el recipiente de vidrio con etanol 98% para reposar nuevamente durante 10 días. Este proceso se repitió en 3 ocasiones. Finalmente, el filtrado se secó en rota evaporador durante 3 horas a 40ºC con una presión de 125 mbar. El secado final del extracto fue en cabina de extracción de gases durante 5 horas a 30ºC.
Identificación cualitativa y cuantificación de los metabolitos secundarios. Con el fin de determinar la composición general de metabolitos secundarios presentes enB. officinalis, se realizó un proceso fitoquímico propuesto por Lock (2016) (Figura 1). Para la fenoles se utilizó la prueba de cloruro férrico; para esteroles y metilesteroles, la de Salkowski; para esteroides y terpenos, la de Liberman-Buchard; para coumarinas, se utilizó la de hidróxido de sodio; para saponinas, la de espuma y para leucoantocianidinas, la de HCl concentrado (Robleset al. 2016, Navarreteet al. 2017).

Cuantificación de polifenoles y flavonoides. Los fenoles y flavonoides son considerados los responsables de la actividad antimicrobiana en plantas (Kappelet al. 2008, De Castroet al. 2010), por lo cual se consideró importante su cuantificación. El contenido de total de polifenoles se determinó por el método Folin-Ciocalteau (Fo-Cio) y se siguió el método propuesto por Ciccoet al.(2009). Se mezclaron 100 µL de ácido gálico (reactivo analítico) con 200 µL del reactivo Folin-Ciocalteau al 10%, después de 4 minutos se agregaron 800 µL de solución acuosa de Na2CO3(700 mM). La mezcla se agitó y calentó en baño maría a 40ºC durante 20 minutos, la curva estándar se preparó con el estándar acido gálico (15, 25, 40, 75, 100, 120 en mg.l-1). Para determinar el contenido de fenoles totales, se expresó en miligramos equivalentes de ácido gálico (EAG) por gramo de extracto, la cuantificación de polifenoles se realizó por triplicado a 720 nm en espectrofotómetro (Thermo Scientific 840-210300).
Además, el contenido total de flavonoides se determinó mediante los métodos propuestos por Nabaviet al.(2008). Se mezclaron 100 µL del estándar catequina (Qe) al 10% con 800 µL de metanol, luego se adicionó 100 µL de AlCl3(10%) junto con 100 µL de acetato de sodio (0,1M), finalmente, se dejaron reposar durante 30 minutos a temperatura ambiente. La curva estándar se preparó al utilizar como estándar catequina (15, 25, 35, 50, 75, 100 y 125 mg.l-1). El total de flavonoides se expresó en miligramos equivalentes de catequina (Qe) por gramo de extracto. La cuantificación de flavonoides se realizó por triplicado a 420 nm en espectrofotómetro.
Identificación molecular de los aislamientos de hongos. Con el fin de caracterizar molecularmente los aislamientos deFusariumsp yAlternariasp de un cepario de hongos de la Universidad Central donde fue realizado el estudio para posteriormente ser conservados en glicerina 15% a una temperatura de -20°C. Los aislados fueron reactivados mediante la siembra en superficie en el medio de cultivo papa, dextrosa-agar (PDA) e incubados a 27°C durante 72 horas. La extracción del ADN de los aislamientos se realizó con el kit de extracción Genomic DNA™ Tissue MiniPrep (Zymo Research, Irvine, EEUU), se siguieron las instrucciones del fabricante y se verificó en gel de agarosa. Posteriormente se realizó una PCR para amplificar la región ITS del ADNr con losprimersuniversales descritos por Whiteet al.(1990). ITS1 (5’- TCCGTAGGTGAACCTGCGG-’3) e ITS4 (5’TCCTCCGCTTATTGATATGC-3’). La mezcla para la amplificación se realizó en un volumen de 90 mL con 12,5 mL de 10X PCRbufferMgCl2(1,5Mm), 1 mL MgCl2, 3,75 mL de dNTP´S, ITS1 e ITS4, 1,25 mL de Taq ADN polimerasa y 1 mL ADN el cual fue estandarizado a 10 ng. La amplificación se realizó en un termociclador (BIO-RAD C1000 thermal cycler) con un ciclo inicial de 94ºC por 5 minutos, 35 ciclos a temperatura de desnaturalización de 94ºC por 1 minuto, una temperatura de anillado de 56ºC por 30 segundos, una temperatura de extensión de 72ºC por 30 segundos y un ciclo final a 72ºC por 7 minutos.
Asimismo, los productos de PCR fueron purificados con el uso del kit de purificación de Zymo Research, Irvine, EEUU. Fueron secuenciados mediante el método Sanger por servicio técnico en el SSIGMOL. La identificación de los aislamientos se determinó mediante el programa BLAST (Basic Local Alignment Search Tool) del NCBI, estos resultados se compraron con la base de datos RDP de Michigan State University con el programa Classifier Fungal ITS Warcup por medio de un porcentaje de similitud de 95%.
Selección del vehículo de siembra. Varios fármacos y extractos experimentales no se disuelven en agua o soluciones salinas y se requiere de otros solventes, como detergentes o aceites vegetales, que sean inocuos a los organismos, este es el caso del Dimetilsulfóxido (DMSO) y Tween 20 que son 2 reactivos comúnmente utilizados como vehículos por la industria farmacéutica (Castroet al. 1995, Sánchez-Recillaset al. 2020). Para la selección del vehículo, se evaluó la actividad antifúngica in vitro del extracto etanólico de las hojas deB. officinalis, mediante la prueba de crecimiento radial por técnica de difusión en agar. Para ello se utilizó como medio de cultivo PDA con el extracto etanólico disuelto en DMSO o en Tween 20, ambos al 5% (Nieto Navarro 2012). Los trozos (6 mm de diámetro) de los aislamientos deFusariumsp yAlternariasp, de 7 días de crecimiento, fueron ubicados en el centro de la caja de Petri para luego ser incubados durante 9 días a 27°C. Cada 3 días se realizó lectura del crecimiento radial del micelio y el proceso fue realizado por triplicado. Como controles negativos se utilizó DMSO al 5% y Tween 20 al 5% en Agar PDA sin de extracto vegetal y, como, control positivo se utilizó un antifúngico comercial, el cual contiene propamocarb-HCl + metalaxyl a una concentración de 36 mg.l-1, según especificaciones del fabricante.
Ensayos de actividad antifúngica del extracto. La actividad antifúngica del extracto de las hojas deB. officinalisse llevó a cabo con DMSO al 5% como vehículo y por la técnica de difusión en agar, con concentraciones de 6, 8, 10, 12, 13, 14, 15 y 16 mg.l-1de extracto vegetal (Nieto Navarro 2012). Para el análisis de los resultados, se calculó el porcentaje de crecimiento micelial o radial respecto al control del medio inoculado con los hongos, se consideró como el 100% del crecimiento radial o 0% de inhibición del crecimiento micelial mediante la siguiente ecuación (Ezziyyaniet al. 2004, Marquez-Vizcainoet al. 2007, Saúlet al. 2011, Bautistaet al. 2016).

Análisis estadístico. Para evaluar el porcentaje de inhibición del crecimientoFusariumsp yAlternariasp frente aB. officinalis, todas las medidas fueron tomadas por triplicado y expresadas como el valor ± la desviación estándar. Además, los datos fueron analizados mediante un análisis de varianza (ANOVA). De continuo, se comprobaron los supuestos de normalidad y homoscedasticidad seguido de una prueba de comparación múltiple de Tukey con el uso de la herramienta IBM spss statistics v25 2017.
Identificación del material vegetal. El material vegetal fue identificado en el laboratorio según la descripción de Galleet al. (1993), De Smet (1993) y Abuet al. (2017) comoBorago officinalis(Figura 2) donde se presenta tallo ramificado, presencia de pubescencia por toda la planta hasta las hojas. Se identificaron hojas alternas, anchas que decrecen en tamaño hacia el ápice de la rama; las hojas basales son pecioladas, ovales, las caulinares, sésiles y lanceoladas. Por su parte las flores que tienen forma de estrella de color azul, con estambres negros (Simpson 1993).

Figura 2. Hojas y flores deBorago officinalis.A) Tallo ramificado, hojas alternas, anchas que decrecen hacia el ápice de la planta. B) Flores deB. officinalisen forma de estrella de color azul, con estambres negros.
Además, se utilizó el servicio de estudio taxonómico para verificar la identificación deB. officinalisrealizado por el Herbario Nacional de Colombia de la Universidad Nacional de Colombia, donde se obtuvo una verificación deBorago officinaliscon designación de muestra BO1 y número de colección 612220.
Identificación cualitativa de metabolitos secundarios. De acuerdo con los protocolos establecidos durante los ensayos cualitativos preliminares, se identificó la presencia de alcaloides, flavonoides, fenoles y saponinas; además, la presencia de esteroles y metilesteroles, esteroides y terpenos, coumarinas y leucoantocianidinas que fue negativa (Tabla 1). Los resultados coincidieron con los obtenidos por Echavarríaet al.(2016) quienes reportan resultados similares a excepción de polifenoles; por otra parte, Leos (2010) reportó la ausencia de flavonoides al aplicar la prueba de H2SO4. Otras investigaciones reportaron, de igual manera, la ausencia de compuestos como esteroles, esteroides y terpenos (Mhamdiet al. 2009, Abuet al. 2017, Saadatianet al. 2017). La presencia de compuestos como los fenoles y flavonoides sugiere queB. officinalispuede presentar distintas propiedades entre las que destacan la capacidad antioxidante, antimicrobiana y antifúngica (Reddyet al. 2007, Sivaet al. 2008, Robleset al. 2016, Carvalhoet al. 2018).

Cuantificación de polifenoles y flavonoides. El contenido total de polifenoles de las hojas deB. officinalisfue de 19,08±0,01 (r2=0,97) reportado en miligramos equivalentes de ácido gálico (EAG) por gramo de extracto. Por otro lado, el contenido de flavonoides de las hojas deB. officinalisfue de 28,12±0,06 (r2=0,99), reportado como miligramos equivalentes de catequina (Qe) por gramo de extracto. El contenido total de polifenoles de las hojas deB. officinalisconcuerda con los resultados obtenidos por Segoviaet al.(2014), en el que sus resultados variaron de 19,16 a 27,49 mg equivalentes de ácido gálico.g-1de extracto, en las hojas deB. officinalisa partir de un extracto etanólico; sin embargo, el contenido total de polifenoles es significativamente menor en comparación con los reportados por Zemmouriet al.(2014), quienes reportaron un contenido total de polifenoles presentes en hojas deB. officinalisa partir de un extracto etanólico de 94,09±1,72 mg equivalentes de ácido gálico.g-1de extracto.
El contenido de polifenoles totales concuerda con el registrado para varias plantas aromáticas y de uso medicinal (Zheng y Wang 2007). Además, el contenido de flavonoides totales difiere de los resultados obtenidos por Zemmouriet al. (2014) en su estudio de la composición química y antioxidante deB. officinalis, pues se obtuvo como resultado 37,6±3,9 miligramos equivalentes de catequina (Qe).g-1de extracto. La presencia de polifenoles y flavonoides en este estudio podrían indicar acción antifungica (De Castroet al. 2010, Leon Duran y Mancheno Cárdenas 2021).
Identificacion molecular de los aislamientos de hongos. Las secuenciaciones de regiones ribosomales con marcadores ITS sugieren que los aislamientos, identificados previamente por su morfología pueden serFusariumsp yAlternariasp. La amplificación de la banda para losprimersutilizados fue la esperada (500 pb) según las secuenciaciones de Villavicencio (2013), Vanegas Berrouetet al.(2014) y Salazar (2016), paraF. oxyspoprumfue de 550 pb mientras que paraAlternariasp fue 580 pb.
El análisis de la secuencia ITS realizado con la herramienta BLASTn del NCBI mostró una identidad de la secuencia del 99,83% paraFusariumsp y la información fue depositada en el GenBank del NCBI con el número de acceso KP942940.1. La secuencia paraAlternariasp mostró una identidad del 99% con varias especies comoAlternaria arborescensyAlternaria alternata(números de acceso GenBank: MK460794.1, JQ910882.1, MK461082.1, MN044802.1), por lo que no se logró especificar claramente la especie y, por tanto, fue denominadaAlternariasp.
Con el fin de constatar los resultados señalados, las secuencias se compararon con la base de datos RDP de Michigan State University, mediante el programa Classifier Fungal ITS Warcup, el cual mostró resultados similares para ambos casos, que sugieren la presencia deF. oxysporumcon un umbral de confianza del 95%; mientras queAlternariasp obtuvo 56% de identidad conAlternaria alternatacon un umbral de confianza del 95%, sin embargo, es definida comoAlternaria_no identificada. Según los resultados, se toma la decisión de no atribuir ninguna especie para el caso deAlternariasp. No obstante, la secuenciación de la región ribosomal con marcadores ITS puede no ser concluyente para la correcta identificación molecular de los aislamientos deFusariumsp yAlternariasp, ya que debido a la gran cantidad de polimorfismo que existe entre especies estrechamente relacionadas, se recomienda el uso de másprimerscomo TEF-1α o RPB2 (Geiseret al. 2004, Salazar-Gonzálezet al. 2016, Rangel-Castilloet al. 2017), razón por la cual se decidió no atribuir ninguna especie para los aislamientos secuenciados.
Selección del vehículo de siembra. El crecimiento radial deFusariumsp yAlternariasp se afectó de manera negativa por el extracto deB. officinalismediante los vehículos DMSO al 5% y Tween 20 al 5%. Sin embargo, el extracto deB. officinalispresentó mayor porcentaje de inhibición para los 2 aislamientos evaluados con DMSO-5% (Figura 3).

En el caso deFusariumsp, los tratamientos se dividieron en 2 grupos estadísticamente diferentes (ANOVA p<0,05) en los 3 primeros días. El primer grupo incluyó los ensayos realizados con DMSO-5% y el control (+) y el segundo grupo incluyó los ensayos con Tween 20-5%. Los tratamientos que conformaron el primer grupo presentaron mayor porcentaje de inhibición donde el control (+) fue el tratamiento más efectivo frente aFusariumsp (64,7±0,5%), seguido por el extracto vegetal disuelto en el vehículo DMSO-5% (55,7±2,0%), mientras que el segundo grupo conformado por el extracto vegetal disuelto en Tween-20 al 5% presentó un porcentaje de inhibición significativamente menor (28,7±1,2%).
En la Figura 3, se observa que la inhibición deB. officinalissobreFusariumsp, disminuye a través del tiempo (6 y 9 días), ya que es el extracto disuelto en DMSO-5% el tratamiento más efectivo frente aFusariumsp (40,0±5,1%) al final del experimento.
Para el caso deAlternariasp se observó que el extracto de las hojas deB. officinalisinhibió el crecimiento en mayor porcentaje con respecto alFusariumsp (Figura 3). Los resultados se dividieron en 2 grupos estadísticamente diferentes (ANOVA p<0,05). El primer grupo (DMSO-5% y control (+)) presentó mayor porcentaje de inhibición donde el control (+) fue el tratamiento más efectivo frente aAlternariasp (71,3±0,5%) seguido por el extracto disuelto en DMSO-5% (62,8±0,6%). El segundo grupo conformado por Tween 20-5% presentó un porcentaje de inhibición menor (53,1±2,5%).
Al igual que para el caso deFusariumsp, la efectividad del extracto de las hojas deB. officinalissobreAlternariasp disminuyó a través del tiempo. Es importante resaltar que por 9 días, se conformaron 3 grupos, el primero formado por el control (+), el segundo por DMSO-5% y tercero por Tween 20 al 5%; donde el control (+) fue el tratamiento más efectivo frente aAlternariasp (53,4±0,3%).
Vehículos de dilución como DMSO funcionan como potenciadores de los extractos vegetales, ya que incrementan la penetración de sus principios activos, además, la asociación de extractos vegetales de origen acuosos, etanólicos y metanólicos aumentó la efectividad, en este caso el porcentaje de inhibición del crecimiento radial para los 2 aislamientos evaluados (Figura 3) (Ravindranet al. 2011, Bobadilla Alvarez y Reyes Castro 2020).
Algunos vehículos, como Tween 20, pueden disminuir la actividad locomotora del extracto al impedir la correcta dilución en el medio inoculado, lo cual reduce su eficiencia (Castroet al. 1995). Recursos como Tween 20 y Tween 80 pueden inactivar compuestos fenólicos que han sido reportados como los encargados de la actividad antimicrobiana presente en los extractos de plantas (Dixon 2001, Akhila 2009). La selección previa del medio de dilución del extracto es importante, ya que estos pueden presentar efecto de inhibición de la actividad biológica del extracto así como efectos tóxicos sobre el organismo evaluado (Jaeschkeet al. 2006, Ravindranet al. 2011).
Aunque DMSO-5% como agente fue más eficiente, DMOS-5% y Tween 20-5% fueron efectivos frente aFusariumsp yAlternariasp, ya que presentaron un porcentaje de inhibición ≥ 20% al cabo de 9 días (Marquez-Vizcainoet al. 2007). Según los resultados observados, se seleccionó como recurso para los ensayos de actividad DMSO-5% pues presentó mayor efectividad sobre la inhibición del crecimiento deFusariumsp yAlternariasp.
Ensayos de actividad antifúngica del extracto etanólico. Los ensayos de la actividad antifúngica del extracto etanólico de las hojas deB. officinalisse realizaron con diferentes concentraciones de extracto con DMSO-5% como agente, para determinar la concentración más efectiva a través del tiempo (3, 6 y 9 días) (Figura 4).

Para el caso deFusariumsp, los tratamientos se dividieron en 6 grupos estadísticamente diferentes (ANOVA p<0,05) y al cabo de 3 días, se observaron los que presentaron mayor porcentaje de inhibición del crecimiento. El grupo conformado por los tratamientos 13, 14, 15 y 16 mg.l-1mostró un porcentaje de inhibición de 100%. Adicionalmente, tratamientos con 12 mg.l-1y 10 mg.l-1presentaron un porcentaje de inhibición de 85,4±8,5% y 75,2±3,0%, respectivamente (Figura 4). La tendencia de disminución de la inhibición del crecimiento se observó conforme se redujo la concentración del extracto, pues fue el último grupo conformado por el tratamiento con concentración de 6 mg.l-1y mostró menor inhibición del crecimiento (39,9±5,7%).
Al cabo de 6 días los tratamientos se dividieron en 7 grupos estadísticamente diferentes (ANOVA p<0,05). El primer grupo conformado por 16 mg.l-1fue el único que presentó un porcentaje de inhibición de 100%. También se observó que la inhibición deB. officinalissobreFusariumsp disminuyó a través del tiempo (6 y 9 días), donde el tratamiento de 16 mg.l-1fue el más efectivo frente aFusariumsp (86,6±2,2%) al final del experimento (Figura 5).

En contraste con los resultados obtenidos por Nieto-Navarro (2012), quien evaluó el efecto antifúngico de varias plantas medicinales entre ellasB. officinaliscon concentraciones similares del extracto sobreFusariumsp, reportó la ausencia de actividad antifúngica. Sin embargo, no reportó uso de un vehículo de dilución del extracto. Castroet al. (1995), Bobadilla-Alvarez y Reyes-Castro (2020) corroboran la importancia en la selección de un medio para ensayos de actividad de extractos vegetales el cual podría mejorar la actividad biológica. Sin embargo,Fusariumsp es un fitopatógeno multiresistente y los extractos vegetales con capacidad antifungica con frecuencia están limitados por el desarrollo de resistencia enzimática o por procesos de sustitución genética.
Para el caso deAlternariasp los tratamientos se dividieron en 3 grupos estadísticamente diferentes (ANOVA p<0,05). Después de 3 días, se observó que presentaron mayor porcentaje de inhibición del crecimiento. El primer grupo se conformó con los tratamientos de mayor concentración (12, 13, 14, 15 y 16 mg.l-1) mediante un porcentaje de inhibición del 100%. El segundo grupo se conformó por tratamientos de 8 y 10 mg.l-1de concentración que presentaron un porcentaje de inhibición de 89,5±2,2% y 85,6±9,0%, respectivamente. El tercer grupo fue conformado con una concentración de 6 mg.l-1y el control (+) que presentaron 71,3±2,5% y 62,8±2,5% (Figura 6).

Al igual que para el caso deFusariumsp,la inhibición deB. officinalissobreAlternariasp disminuyó a través del tiempo (6 y 9 días). Después de 6 días, los tratamientos se dividieron en 6 grupos estadísticamente diferentes, donde el primer grupo fue conformado por los tratamientos de 14, 15 y 16 mg.l-1los cuales presentaron más efectividad frente aAlternariasp (100%). El tratamiento más efectivo al final de 9 días fue 16 mg.l-1frente aAlternariasp (90,3±0,96%) (Figura 7).

Se evidenció un contraste con los resultados obtenidos por Arévalo (2009), quien solo reportó actividad antifungica frente aAlternariasp. Khafariet al.(2014) evaluaron el efecto deB. officinalissobreAlternariasp en una concentración de 5 mg diluidos sobre discos de papel, ya que reportaron la ausencia de actividad antifúngica, a diferencia de los obtenidos en el presente estudio, que fue la concentración mínima evaluada de 6 mg.l-1con el uso de la técnica de dilución en agar con vehículo de dilución (DMSO-5%).
La inhibición observada se considera altamente efectiva de acuerdo con Marquez-Vizcainoet al.(2007) al presentar un porcentaje de ≥20%. Sin embargo, el extracto deB. officinalismostró la presencia de actividad fungistática, ya que el crecimiento deFusariumsp yAlternariasp fue reactivado al cabo de 3 días para la mayoría de las concentraciones evaluadas, excepto 16 mg.l-1donde el crecimiento fue reactivado después 6 días (Soyluet al. 2010, Moreno 2011).
Los resultados obtenidos pueden relacionarse con la presencia de compuestos fenólicos por parte deB. officinalis,comúnmente relacionados con la actividad antimicrobiana de los extractos vegetales (Gattoet al.2011, Rodriguez-Maturinoet al. 2015, Fabrikovet al. 2019). La presencia de compuestos fenólicos en el extracto deB. officinaliscorroboraron la presencia de la actividad antifúngica que actúa como repelente, además de inhibir la acción enzimática por oxidación de las topoisomerasas implicadas en procesos de transcripción y reparación del ADN (Lizcano González 2007, De Castroet al. 2010, Azueroet al. 2016, Mesaet al.2019). Además, atacan la membrana citoplasmática del patógeno, lo cual afecta la capacidad selectiva y permite el escape de componentes intracelulares (Nychas 1995).
La pérdida de actividad fungicida del extracto de las hojas deB.officinalissobreFusariumsp yAlternariasp respondió a sus mecanismos de resistencia entre los que destaca la resistencia metabólica por parte de especies patógenas mediante la acción enzimática. Incluso para el caso de hongos y malezas son capaces de reducir la sensibilidad en el sitio de acción de manera que antifúngico no pueda fijarse al sitio de acción, al inhibir o reducir significativamente su efectividad (Hernández 2012).
Existe un riesgo intrínseco en la aplicación de las dosis de los extractos vegetales o fungicidas, además, de la subdivisión de las mismas, ya que se ejerce mayor presión de selección, lo cual favorecería la supervivencia de una parte de la población de hongos menos sensibles a los principios activos aplicados, en ese sentido el fungicida ejerce presión sobre el hongo y mata solo a la población sensible (Hobbelenet al. 2011, Gressel 2011, Hollomon 2012, Grimmeret al. 2015, Carmona y Sautua 2017).
Eidiet al.(2014) reportan la presencia de actividad antifúngica deB. officinalisen 3 especies de hongos fitopatógenos del género deAspergillus(A. fumigatus,A. nigeryA. flavus), resultados que corroboran el potencial antifúngico por parte deB. officinalis. Gattoet al.(2011) también reportaron la presencia de actividad antifúngica deB. officinalissobreBotrytis cinérea,Monilia laxa,Aspergillus niger,Aspergillus carbonarius, entre otros.
El extracto etanólico de las hojas deBorago officinalisexpuso un alto contenido de fenoles y flavonoides totales que hacen de esta planta una especie promisoria por los beneficios que podría ofrecer en el control biológico de hongos fitopatógenos.
El extracto etanólico de las hojas deBorago officinalisfue efectivo en el control in vitro deFusariumsp yAlternariasp, con resultados similares al fungicida comercial propamocarb-HCl + metalaxyl, el cual es de uso común.
Se demostró la actividad antifúngica del extracto etanólico de las hojas deBorago officinalis, lo que sugiere que su aplicación puede ser una alternativa para su empleo en el manejo agroecológico de los hongos fitopatógenos.
La investigación reportó la evaluación del extracto etanólico deBorago officinalisplanta considerada como maleza en regiones del país no obstante, se evidencia el valor agregado que puede ofrecer dentro de la cadena agroproductiva.
Se recomienda realizar el fraccionamiento y obtención estructural de los metabolitos secundarios en Borago officinalis que presenten actividad antifúngica sobre Fusarium sp y Alternaria sp.
Asimismo, evaluar la actividad antifúngica de B. officinalis sobre otras especies de hongos fitopatógenos. Es recomendable establecer la concentración mínima inhibitoria del extracto y realizar ensayos en aplicaciones sucesivas con el fin de evitar que los hongos creen resistencia a los metabolitos secundarios presentes en el extracto.
Las personas autoras agradecen a la Facultad de Ingeniería y Ciencias Básicas de la Universidad Central donde fue llevado a cabo el estudio. También a María Camila Escobar, Gladys Cardona, Marcela Carrillo, William Quintero del instituto SINCHI y a Jorge Robles de la Pontificia Universidad Javeriana por su ayuda y orientación en este trabajo.